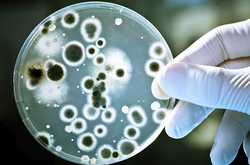
На фоне постепенного повышения температуры внешней среды создают условия для вспышек заболеваний кишечной группы

Для создания фейков Россия пытается привлечь иностранные СМИ – разведка

Так называемый «пресс-тур» также предусматривает выезд группы из Ростова-на-Дону и посещение журналистами Херсона, Новой Каховки, Скадовска, Армянска и Донецка
Осознав, что мировая общественность больше не верит лживым сообщениям российских телеканалов, кремлевские пропагандисты решили привлечь к своей деятельности европейских журналистов и мировые СМИ.
По данным военной разведки Украины, департамент информации и массовых коммуникаций министерства обороны страны-оккупанта срочно готовит «пресс-тур» иностранных журналистов на временно оккупированные территории Украины.
С 18 по 21 мая оккупанты планируют показать представителям СМИ разрушенные районы Мариуполя. Чтобы обвинить Украину в разрушении города и массовых убийствах мирных жителей, российские пропагандисты уже завезли в Мариуполь обломки украинских боеприпасов, собранных из всех оккупированных районов Донецкой области, и готовят завезенных из Донецка и Горловки местных очевидцев, которые будут рассказывать журналистам о «преступлениях» защитников Мариуполя.
Так называемый «пресс-тур»также предусматривает выезд группы из Ростова-на-Дону и посещение журналистами Херсона, Новой Каховки, Скадовска, Армянска и Донецка, где запланирована встреча с кремлевской марионеткой Денисом Пушилиным.
К участию в «пресс-туре» министерство обороны РФ пытается привлечь представителей средств массовой информации из Франции, США, ФРГ, Японии, Греции, КНР, Беларуси, Индии, Венесуэлы, Болгарии и ОАЭ.
В разведке предостерегают иностранных журналистов о планах пропагандистов страны-агрессора сделать их соучастниками создание фейковых материалов и напоминают об уголовной ответственности за незаконное пересечение государственной границы Украины и проникновение на территорию независимого государства.
Напомним, ранее Главное управление разведки Министерства обороны Украины перехватило телефонный разговор двух жителей «ДНР», которые жаловались на массовые потери на фронте.
Также разведка обнародовала перехват разговора оккупанта, что ярко демонстрирует настроение в российской армии – желание уйти с войны любой ценой.

Коментарі — 0